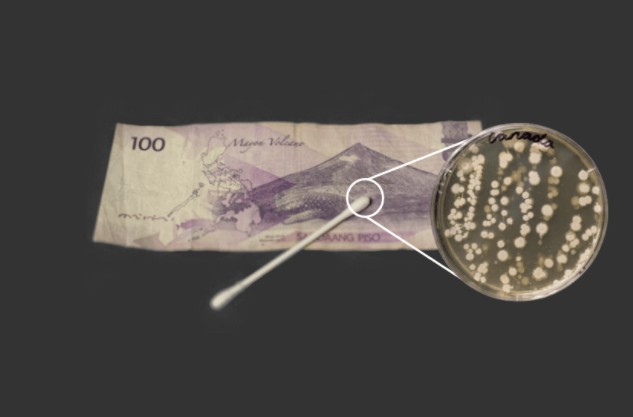
图片

如果您的钱包里有钞票,那么在触摸它们之前,您可能需要三思而后行!
因为..有证据表明加拿大的纸币是世界上“最肮脏的货币”。
Gambling.com公布了最新的货币研究数据,结果表明,纸币中隐藏着很多细菌!

你知道吗,一张现金平均每年会易手110次!
因此,请想象一下在货币表面上藏有多少细菌和令人讨厌的病毒。
赌场每年都会收到来自世界各地的人们的,数以百万计的现金。由此,Gambling.com对钱币上的细菌进行了研究。
该研究从世界各地收集了20种最常用的赌场货币,并与微生物学家合作进行了拭子测试,以查明现金中隐藏的细菌是什么类型。
实验室的结果令人惊讶,研究人员甚至在一些纸币中发现了引起食物中毒,肺炎和癣的细菌菌株。
由微生物学家对加拿大的现金进行的拭子测试中,发现了209个细菌菌落,这些细菌“很舒适”让加币成为了最脏的细菌币。

巴西的纸币以118个细菌菌落,位居第二

中国香港的纸币以42个细菌菌落,位居第三

|
a
塑料币容易有细菌?
- [59] (2021-03-25 23:16:01)
|